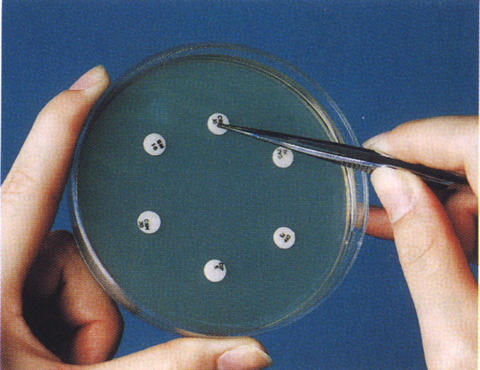

導航
導航
抗生素耐藥是當今人類面臨的最重要的健康問題之一。由于細菌出現(xiàn)抗生素耐藥性,曾經(jīng)可以用抗生素有效治療的感染越來越難以治療,特別是在免疫力低下的患者中,如糖尿病患者或癌癥患者,以及流感后繼發(fā)細菌感染的老年人。亂用和過量使用抗生素是導致這種抗生素耐藥性出現(xiàn)的重要原因之一。
沒有哪個國家能幸免于這個問題。世衛(wèi)組織估計,到2050年,將有1000萬人死于抗藥性感染,今年公布的數(shù)字顯示,抗藥性感染在去年增加了約9%。
如果我們不解決這個問題,我們將回到人類因諸如割傷或刮傷之類的簡單事情而死亡的時代,也會產(chǎn)生由于風險過高,必須取消髖關(guān)節(jié)置換等常規(guī)手術(shù)的現(xiàn)象。
5月26日,WHO公布了2020年全球抗生素耐藥性和使用監(jiān)測系統(tǒng)(GLASS)報告,來自全球66個國家64000多個監(jiān)測點的數(shù)據(jù)顯示,抗生素耐藥國家數(shù)量創(chuàng)下新高,越來越多的細菌感染對手頭的治療藥物產(chǎn)生了抗藥性。
抗藥性菌株引起的感染在不同國家、地區(qū)之間有很大差異。8個低收入國家和15個中低收入國家的比例高于13個中高收入國家和29個高收入國家。報告的感染大多是尿路感染(79%),其次是血液感染(20%)。最常報告的耐藥菌是大腸桿菌、肺炎克雷伯菌、金黃色葡萄球菌和肺炎鏈球菌,其次是沙門氏菌。
分別有25個和49個國家、地區(qū)報告了耐甲氧西林金黃色葡萄球菌和對第三代頭孢菌素耐藥的大腸桿菌感染。觀察到的耐甲氧西林金黃色葡萄球菌的中位感染率為12.11%(IQR 6.4-26.4),對第三代頭孢菌素耐藥的大腸桿菌的中位感染率為36.0%(IQR 15.2-63.0)。
經(jīng)常用于治療尿路感染或腹瀉等常見感染的抗生素高耐藥率表明,世界上或許已經(jīng)沒有解決這些疾病的有效方法。例如,在33個國家的報告中,環(huán)丙沙星(一種常用于治療尿路感染的抗生素)耐藥率為8.4%到92.9%不等。
掃二維碼用手機看
河南海美迪生物技術(shù)有限公司
公司地址:河南省濮陽縣鐵丘路路南中稹綠探院內(nèi)3號樓
聯(lián)系電話:13137349799
E-mail:[email protected]
河南利飛馳生物技術(shù)有限公司
公司地址:河南省濮陽縣鐵丘路路南中稹綠探院內(nèi)3號樓
聯(lián)系電話:17310820029
E-mail:[email protected]
? 2021 河南海美迪生物技術(shù)有限公司 ALL Rights Reserved 備案號:豫ICP備2023018085號 技術(shù)支持:新網(wǎng)